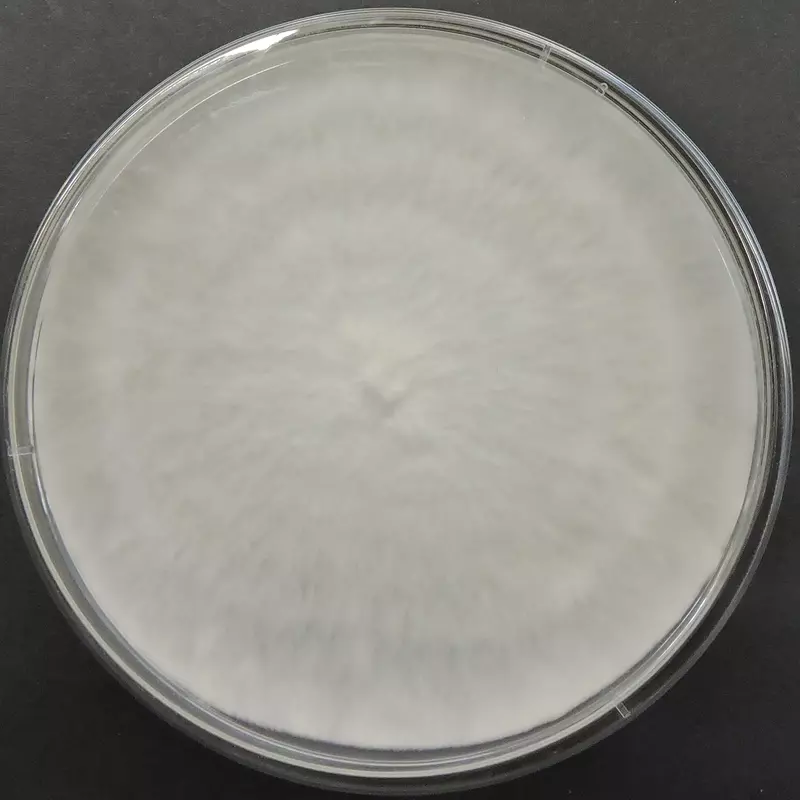

Hypsizygus ulmarius (Elm Oyster Mushroom) โ Pure Culture Plate
High-quality Hypsizygus ulmarius (Elm Oyster Mushroom) pure culture plate for commercial, educational, and gourmet mushroom cultivation. Known for its large white fruiting bodies, robust growth, and adaptability to diverse climates, this strain is perfect for professional and research use.
๐ Proudly prepared and stored at Agripie Agrosystem LLP, India ๐ฎ๐ณ
The Hypsizygus ulmarius (Elm Oyster Mushroom) โ Pure Culture Plate offers a verified, contamination-free strain for reliable performance in spawn production and fruiting trials.
This species, also called Elm Oyster, is recognized for its meaty texture, mild savory flavor, and vigorous colonization on agricultural waste substrates like straw, sawdust, and sugarcane bagasse.
It thrives in both tropical and temperate climates, making it an excellent choice for Indian and Southeast Asian mushroom farms. With high yields, fast colonization, and strong resistance to contamination, itโs suitable for commercial growers, training centers, and laboratories.
Features:
Authentic Hypsizygus ulmarius strain (Elm Oyster Mushroom)
Vigorous mycelial growth and strong fruiting potential
Suitable for a wide range of agro-waste substrates
Excellent adaptability to warm climates
Meaty, mild-flavored mushrooms ideal for gourmet cuisine
100% pure, contamination-free culture verified under sterile conditions
๐ Proudly prepared and stored at Agripie Agrosystem LLP, India ๐ฎ๐ณ

|
| 
